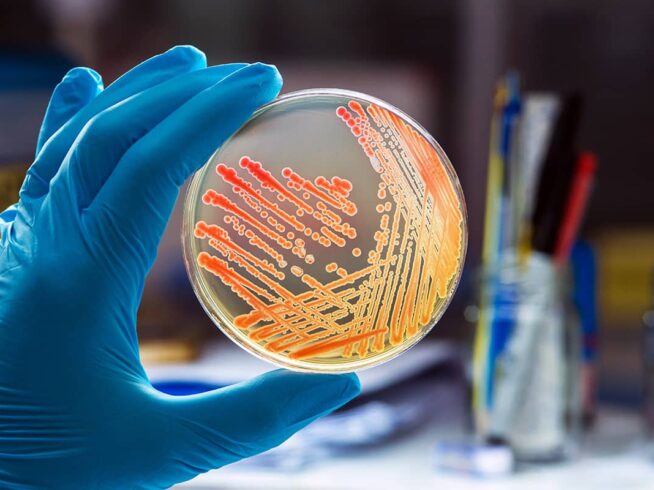

Unlock the Power of Targeted Healthcare Outreach: Healthcare Mailing List from United & Sterling Solutions LLC
Connect with the Entire Spectrum of Healthcare Professionals
In the ever-evolving world of healthcare, targeted communication is essential for success. United & Sterling Solutions LLC offers a comprehensive and meticulously curated Healthcare Mailing List, providing a direct channel to connect with a wide range of healthcare professionals, from physicians and nurses to administrators and allied health professionals.
Why Choose Our Healthcare Mailing List?
-
Unparalleled Accuracy: Our database undergoes a rigorous multi-point verification process, ensuring the contact information you receive is current, reliable, and adheres to all applicable regulations. Eliminate wasted efforts and establish connections with healthcare professionals who are actively engaged in their respective fields.
-
Extensive Coverage: Our list encompasses the entire spectrum of healthcare professionals, including:
- Physicians: Specialists and general practitioners across all medical disciplines.
- Nurses: Registered nurses, nurse practitioners, and specialized nurses.
- Allied Health Professionals: Therapists, technicians, pharmacists, and more.
- Healthcare Administrators: Hospital executives, clinic managers, and healthcare decision-makers.
- Researchers & Scientists: Individuals involved in clinical trials, drug development, and medical research.
-
Targeted Segmentation: Strategically target your outreach based on:
- Job Title & Specialty: Reach specific professionals within their area of expertise.
- Location & Demographics: Focus on specific regions, healthcare settings, or patient populations.
- Professional Affiliations: Connect with members of specific medical associations and organizations.
-
Multi-Channel Engagement: Our Healthcare Mailing List isn’t just about direct mail. Leverage it to fuel your multi-channel marketing strategy, including personalized email campaigns, targeted social media advertising, and impactful telemarketing initiatives.
Empower Your Outreach Strategy
-
Pharmaceutical & Biotech Companies: Launch precisely targeted campaigns for new medications, therapies, and clinical trials. Reach the healthcare professionals who prescribe medications, administer treatments, and participate in research studies.
-
Medical Device & Equipment Manufacturers: Introduce innovative medical technologies, diagnostic tools, and treatment solutions to healthcare providers across various specialties.
-
Healthcare IT & Software Providers: Showcase your electronic health record (EHR) systems, practice management software, telemedicine platforms, and other digital health solutions to healthcare organizations and professionals.
-
Healthcare Staffing & Recruitment Agencies: Connect with healthcare professionals seeking new career opportunities. Fill critical vacancies and connect talented individuals with the right organizations.
-
Continuing Medical Education (CME) Providers: Offer high-quality educational programs, conferences, and workshops to healthcare professionals seeking to enhance their knowledge and skills.
-
Healthcare Consulting & Advisory Firms: Provide your expertise in healthcare management, quality improvement, regulatory compliance, and revenue cycle management to healthcare organizations and leaders.
-
Insurance Providers & Payers: Promote your health insurance plans, wellness programs, and benefit packages to healthcare professionals and organizations.
-
Medical Publishers & Media Companies: Increase readership and subscriptions by targeting your content to healthcare professionals who are eager to stay informed about the latest medical advancements and research findings.
Data Security & Compliance
At United & Sterling Solutions LLC, we prioritize data security and adhere to all relevant privacy regulations, including HIPAA. Your peace of mind is our commitment.
Partner with United & Sterling Solutions LLC
Maximize your outreach potential by connecting with the diverse network of healthcare professionals who drive the industry forward. Our Healthcare Mailing List is your key to establishing meaningful relationships and achieving your marketing goals.
Request a Free Quote: Let us tailor a solution that aligns with your specific needs and budget.
Elevate your outreach. Empower healthcare connections. Achieve results with United & Sterling Solutions LLC.
Remember:
The healthcare industry is constantly evolving, with new challenges and opportunities emerging every day. Partnering with United & Sterling Solutions LLC ensures your message reaches the right healthcare professionals at the right time,enabling you to make a lasting impact on the industry and the patients it serves. Contact us today and unlock the potential of precision targeting in the healthcare landscape.